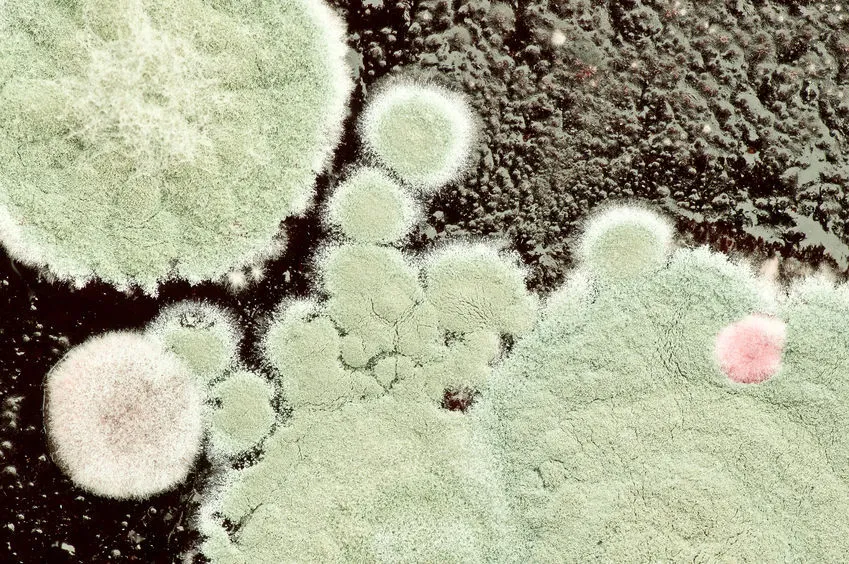
grzyby pleśniowe alergeny

Wielu alergików z utęsknieniem czeka na jesień, licząc na ulgę po sezonie pylenia drzew i traw. Jednak dla mieszkańców Szczecina, jak i innych regionów Polski, jesienne miesiące, zwłaszcza listopad, wciąż mogą stanowić wyzwanie. Dzieje się tak za sprawą innych, mniej oczywistych alergenów, które w tym okresie stają się aktywne. Ten artykuł dostarczy Ci aktualnych informacji o tym, co pyli w Szczecinie pod koniec roku, pomoże zrozumieć przyczyny Twoich objawów i podpowie, jak skutecznie sobie z nimi radzić.
Zarodniki grzybów pleśniowych i roztocza kurzu domowego co pyli w Szczecinie w listopadzie?
- Głównym alergenem w listopadzie w Szczecinie są zarodniki grzybów pleśniowych (Cladosporium, Alternaria), których stężenie wzrasta w wilgotne dni.
- Wraz z rozpoczęciem sezonu grzewczego, roztocza kurzu domowego stają się kluczowym problemem, nasilając objawy alergii w zamkniętych pomieszczeniach.
- Pojedyncze ziarna pyłku ambrozji mogą być sporadycznie obecne w powietrzu, zwłaszcza na początku miesiąca, transportowane przez wiatr.
- Specyfika Szczecina, z dużą ilością terenów zielonych i bliskością wody, sprzyja dłuższemu utrzymywaniu się zarodników pleśni.
- Artykuł pomoże odróżnić objawy alergii od jesiennego przeziębienia i podpowie, jak skutecznie radzić sobie z alergenami.
Alergiku, uwaga! Co naprawdę pyli w Szczecinie pod koniec roku?
Choć kalendarz pylenia większości drzew i traw dobiegł końca, jesień w Szczecinie potrafi zaskoczyć alergików. Wilgotny, często mglisty klimat oraz specyfika terenów zielonych miasta sprawiają, że pewne alergeny nie odpuszczają. Zamiast pyłków drzew i traw, na pierwszy plan wysuwają się inne, często niedoceniane czynniki, które mogą wywoływać uciążliwe objawy. Warto wiedzieć, co kryje się w powietrzu, aby móc skutecznie chronić swoje zdrowie.
Sezon pylenia drzew liściastych i traw już dawno za nami, co dla wielu alergików oznacza wytchnienie. Jednak jesień, a szczególnie jej późniejsza faza, niesie ze sobą nowe wyzwania. W powietrzu zaczynają dominować inne substancje, które mogą być równie silnymi alergenami. W Szczecinie, ze względu na jego specyficzne położenie i klimat, szczególną uwagę należy zwrócić na zarodniki grzybów pleśniowych oraz roztocza kurzu domowego. Choć ambrozja zakończyła swój główny okres pylenia, jej pojedyncze ziarna mogą jeszcze sporadycznie pojawiać się w powietrzu, zwłaszcza na początku listopada.
Wielu z nas kojarzy alergię głównie z wiosennym i letnim okresem pylenia roślin. Zapominamy jednak, że jesień i zima również mają swoich "winowajców". Szczególnie w wilgotnym klimacie, jakim charakteryzuje się Szczecin, zarodniki grzybów pleśniowych mogą stanowić poważny problem. Do tego dochodzą roztocza kurzu domowego, które w sezonie grzewczym znajdują idealne warunki do rozwoju w naszych domach. Zrozumienie, co dokładnie pyli w tym okresie, jest pierwszym krokiem do skutecznego radzenia sobie z objawami.
Główni podejrzani na liście alergenów w listopadzie co musisz wiedzieć?
W listopadzie w Szczecinie głównym alergenem wziewnym są zarodniki grzybów pleśniowych. Szczególnie dwa rodzaje Cladosporium i Alternaria są odpowiedzialne za większość jesiennych reakcji alergicznych. Ich stężenie w powietrzu znacząco wzrasta w dniach charakteryzujących się wysoką wilgotnością, mgłą, a także wtedy, gdy temperatury utrzymują się powyżej zera. Objawy wywoływane przez pleśnie są często podobne do tych powodowanych przez pyłki: nieżyt nosa z wodnistą wydzieliną, swędzenie i łzawienie oczu, a u osób z astmą mogą nasilać się duszności i kaszel. Niestety, zarodniki pleśni są często "niewidzialne" i trudniejsze do uniknięcia niż pyłki roślin.
Choć główny sezon pylenia ambrozji przypada na sierpień i wrzesień, nie można jej całkowicie zignorować w listopadzie. Pojedyncze ziarna pyłku tej silnie uczulającej rośliny mogą być transportowane przez wiatr na duże odległości i utrzymywać się w powietrzu nawet na początku listopada. Szczególnie w dni o mniejszej ilości opadów i umiarkowanej wilgotności, możemy być narażeni na jej alergeny. Warto o tym pamiętać, jeśli objawy alergii utrzymują się mimo braku typowego pylenia.
Gdy tylko rozpoczyna się sezon grzewczy, a nasze mieszkania stają się cieplejsze i często rzadziej wietrzone, roztocza kurzu domowego zaczynają świętować. Choć nie są to pyłki w tradycyjnym rozumieniu, stanowią one kluczowy alergen całoroczny, którego znaczenie w kontekście objawów alergicznych drastycznie wzrasta jesienią i zimą. Ciepłe i wilgotne środowisko w naszych domach sprzyja ich namnażaniu, prowadząc do nasilenia kataru, kaszlu, problemów z zatokami czy zmian skórnych u osób uczulonych.

Kalendarz pylenia dla Szczecina czego spodziewać się pod koniec roku?
Podsumowując, listopad w Szczecinie to przede wszystkim czas dominacji zarodników grzybów pleśniowych, takich jak Cladosporium i Alternaria, których stężenie jest najwyższe w wilgotne i ciepłe dni. Choć sezon pylenia ambrozji jest już za nami, pojedyncze ziarna mogą być jeszcze obecne w powietrzu, zwłaszcza na początku miesiąca. Równocześnie, wraz z rozpoczęciem sezonu grzewczego, rośnie znaczenie roztoczy kurzu domowego jako głównego alergenu w zamkniętych pomieszczeniach.
Zanim tradycyjny sezon pylenia rozpocznie się na nowo, warto wiedzieć, czego można spodziewać się w kolejnych miesiącach. Już pod koniec stycznia lub na początku lutego w Szczecinie zazwyczaj zaczyna pylić leszczyna, a nieco później olsza. Te drzewa rozpoczynają nowy cykl pylenia, sygnalizując powrót wiosny i konieczność ponownego przygotowania się na walkę z alergią.
Specyficzne położenie Szczecina, z jego licznymi terenami zielonymi, parkami i bliskością wód, ma znaczący wpływ na lokalny kalendarz pylenia. Wilgotny klimat sprzyja rozwojowi grzybów pleśniowych, a także może wpływać na dłuższe utrzymywanie się zarodników w powietrzu. Warto brać pod uwagę te czynniki, planując aktywności na świeżym powietrzu, zwłaszcza w okresach zwiększonej wilgotności.
Objawy alergii w listopadzie jak odróżnić uczulenie od jesiennego przeziębienia?
Typowe objawy alergii, które w listopadzie mogą być mylone z przeziębieniem, obejmują:
- Katar: zazwyczaj wodnisty, przezroczysty, czasem obfity.
- Kaszel: suchy, męczący, często nasilający się w nocy.
- Swędzenie oczu, łzawienie, zaczerwienienie spojówek.
- Świąd nosa, gardła, podniebienia.
- Czasami kichanie seriami.
- U niektórych osób mogą pojawić się objawy ze strony układu oddechowego, takie jak duszności czy świszczący oddech.
Kluczową różnicą jest często długotrwałość objawów alergia może trwać tygodniami lub miesiącami, podczas gdy przeziębienie zazwyczaj ustępuje po 7-10 dniach. Warto również zwrócić uwagę na inne czynniki.
| Cecha | Alergia | Przeziębienie/Grypa |
|---|---|---|
| Gorączka | Zazwyczaj nieobecna | Często obecna, zwłaszcza przy grypie |
| Czas trwania objawów | Długotrwałe (tygodnie, miesiące), nawracające | Krótkotrwałe (kilka dni do 1-2 tygodni) |
| Rodzaj wydzieliny z nosa | Wodnista, przezroczysta | Początkowo wodnista, później gęstsza, często żółta lub zielona |
| Ból gardła | Rzadko, zazwyczaj związany ze spływaniem wydzieliny | Często, jako jeden z pierwszych objawów |
| Bóle mięśni i stawów | Rzadko | Często, szczególnie przy grypie |
| Świąd (oczy, nos, gardło) | Bardzo częsty | Rzadko |

Praktyczny poradnik dla alergika w Szczecinie jak przetrwać listopad?
"Pamiętaj, że świadomość i odpowiednie przygotowanie to klucz do komfortowego przetrwania sezonu alergicznego, nawet gdy tradycyjne pyłki ustępują miejsca innym alergenom."
Aby być na bieżąco z aktualną sytuacją pylenia w Szczecinie, warto korzystać z dostępnych narzędzi:
- Aplikacje mobilne: Istnieje wiele aplikacji dedykowanych alergikom, które dostarczają prognozy pylenia w czasie rzeczywistym, często z podziałem na konkretne regiony.
- Serwisy internetowe: Wiele portali pogodowych i zdrowotnych oferuje sekcje poświęcone alergiom, zawierające mapy pylenia i prognozy dla poszczególnych miast, w tym Szczecina.
- Stacje monitoringu: W niektórych miastach działają stacje monitorujące stężenie pyłków, których dane są publikowane online.
Aby skutecznie zmniejszyć stężenie zarodników pleśni i roztoczy kurzu domowego w mieszkaniu, warto zastosować się do poniższych wskazówek:
- Regularne wietrzenie: Nawet jesienią, krótkie, ale intensywne wietrzenie pomieszczeń (kilka razy dziennie po kilka minut) jest kluczowe.
- Kontrola wilgotności: Utrzymuj wilgotność powietrza w domu na poziomie 40-50%. Pomocne mogą być osuszacze powietrza, szczególnie w łazience i kuchni.
- Częste sprzątanie: Regularne odkurzanie (najlepiej odkurzaczem z filtrem HEPA), ścieranie kurzu wilgotną ściereczką i mycie podłóg pomoże usunąć alergeny z powierzchni.
- Pranie pościeli: Pierz pościel, ręczniki i zasłony w temperaturze co najmniej 60°C, aby zabić roztocza.
- Odpowiednia temperatura: W pomieszczeniach, w których śpisz, utrzymuj niższą temperaturę (ok. 18-20°C), co utrudnia rozwój roztoczy.
- Unikanie wilgoci: Susz pranie na zewnątrz lub w dobrze wentylowanym pomieszczeniu, usuwaj pleśń z łazienki i kuchni.
Planując spacery po Szczecinie w listopadzie, warto dostosować je do panujących warunków. Najlepszym momentem na wyjście na zewnątrz są dni po deszczu, kiedy to opady deszczu skutecznie oczyszczają powietrze z zarodników pleśni i pyłków. Należy unikać spacerów w dni mgliste i wilgotne, kiedy stężenie pleśni jest najwyższe. Szczególną ostrożność należy zachować w pobliżu terenów zielonych, parków i lasów, zwłaszcza po okresie opadów, gdy wilgotność jest wysoka. Krótkie, ale częste spacery w ciągu dnia mogą być lepszym rozwiązaniem niż jeden długi.
Oczyszczacz powietrza może być bardzo dobrą inwestycją dla alergika mieszkającego w Szczecinie, zwłaszcza w kontekście problemu roztoczy i zarodników pleśni. Urządzenia te, wyposażone w filtry HEPA, są w stanie skutecznie wyłapywać z powietrza cząsteczki alergenów, w tym zarodniki grzybów i odchody roztoczy. Zaletą jest znacząca poprawa jakości powietrza w pomieszczeniach, co przekłada się na zmniejszenie objawów alergicznych. Wadą może być koszt zakupu oraz konieczność regularnej wymiany filtrów. Warto rozważyć zakup, jeśli domowe metody walki z alergenami nie przynoszą wystarczającej ulgi, a objawy nasilają się w zamkniętych pomieszczeniach.
Przeczytaj również: Ile kosztowało lotnisko w Radomiu? Rozbijamy 800 mln zł.
Twoja droga przez jesienne pylenie w Szczecinie co dalej?
Mam nadzieję, że ten artykuł pomógł Ci rozwiać wątpliwości dotyczące tego, co pyli w Szczecinie pod koniec roku, i dostarczył praktycznych wskazówek, jak radzić sobie z jesiennymi alergenami. Zrozumienie specyfiki pylenia w tym okresie, od zarodników pleśni po roztocza, to klucz do skutecznego zarządzania objawami i poprawy jakości życia.
Kluczowe wnioski na jesień
- Listopad w Szczecinie to przede wszystkim czas zarodników grzybów pleśniowych (Cladosporium, Alternaria) i rosnącego znaczenia roztoczy kurzu domowego w sezonie grzewczym.
- Choć główny sezon pylenia ambrozji minął, pojedyncze ziarna mogą być jeszcze obecne w powietrzu, zwłaszcza na początku miesiąca.
- Specyfika klimatu i terenów zielonych Szczecina sprzyja utrzymywaniu się alergenów, dlatego warto śledzić aktualne komunikaty pyłkowe.
- Rozpoznanie objawów alergii i odróżnienie ich od przeziębienia jest kluczowe dla podjęcia odpowiednich działań.
Z mojego doświadczenia wynika, że największą różnicę w komforcie życia jesienią robi połączenie świadomości alergenów z proaktywnymi działaniami w domu i na zewnątrz. Pamiętajcie, że regularne wietrzenie, kontrola wilgotności i dbałość o czystość otoczenia to fundamenty, które pomagają zminimalizować ekspozycję na zarodniki pleśni i roztocza. Nie zniechęcajcie się, jeśli objawy czasem wracają kluczem jest konsekwencja i dostosowywanie strategii do aktualnych warunków.
A jakie są Wasze doświadczenia z jesienną alergią w Szczecinie? Które z wymienionych alergenów sprawiają Wam najwięcej problemów i jakie macie sprawdzone sposoby na radzenie sobie z nimi? Podzielcie się swoimi spostrzeżeniami i poradami w komentarzach poniżej!
